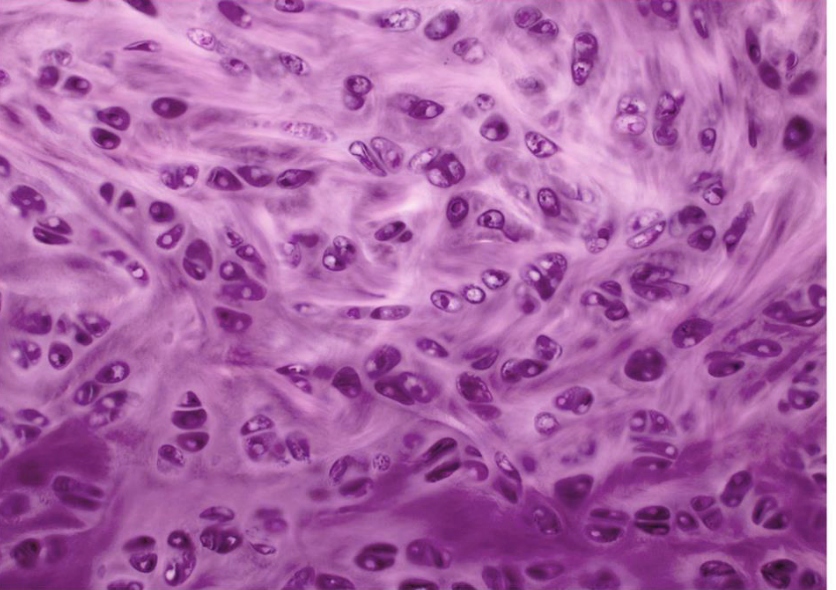
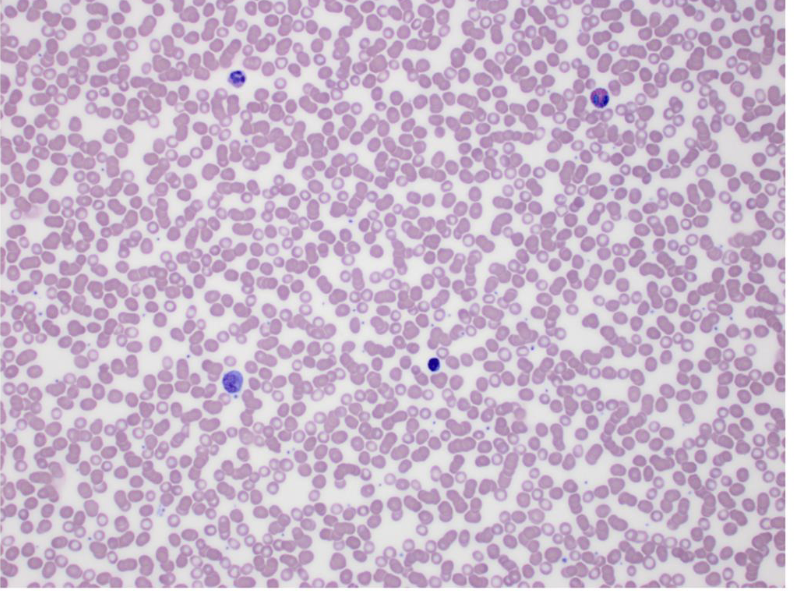

Imperialism
Rise in Nationalism
• During the French and Industrial Revolution, nationalism continued to inspire nations to increase their political and economic power.
• Nationalism became the ideal force in the political, economic, and cultural life in the world, becoming the first universal ideology-organizing all people into a nation state.
Nationalism Defined
• The strong belief that the interest of a particular nation-state is of primary importance.
o Nation-State – a state where the vast majority shares the same culture and is conscious of it. It is an ideal in which cultural boundaries match up with political ones.
• As an ideology, it is based on the idea that the individual’s loyalty and devotion to the nation-state surpass other individual/group interests.
• Exalting one nation’s belief above all others and placing primary emphasis on promotion of its culture and interests, excluding the interests of others.
Changing the World through a Nationalistic Vision
• The French Revolution significantly changed the political world and how countries govern.
• The Industrial Revolution significantly changed the economic world.
• The Age of Imperialism (1870-1914) dramatically changed the political, economic, and social world.
What is Imperialism?
• Imperialism- The policy of extending the rule of authority of an empire or nation over foreign countries, or of acquiring and holding colonies and dependencies. Power and influence are done through diplomacy or military force.
Reasons for Imperialism
• There are 5 main motives for empires to seek to expand their rule over other countries or territories:
1. Exploratory
• Imperial nations wanted to explore territory unknown to them.
• The main purpose for this exploration of new lands was for resource acquisition, medical or scientific research.
o Charles Darwin
• Other reasons:
o Cartography (map making)
o Adventure
2. Ethnocentric
• Europeans acted on the concept of ethnocentrism
o Ethnocentrism- the belief that one race or nation is superior to others.
• Ethnocentrism developed out of Charles Darwin’s “survival of the fittest” theory. Philosophers used the theory to explain why there were superior races and inferior races.
o This became known as Social Darwinism.
• Most imperial nations believed that their cultural values or beliefs were superior to other nations or groups.
• Believed imperial conquest would bring successful culture to inferior people.
3. Religious
• Imperial expansion promoted a religious movement of people setting out to convert new members of conquered territories.
• With the belief that Christianity was superior, missionaries believed it was their duty to spread Christianity to the world.
• Christian missionaries established churches, and in doing so, they spread Western culture values as well.
• Typically, missionaries spread the imperial nation's language through education and religious interactions.
4. Political
• Patriotism and Nationalism helped spur our imperial growth, thus creating competition against other supremacies.
• It was a matter of national pride, respect, and security.
• Furthermore, European rivalry spurred nations for imperial conquest. Since land equaled power, the more land a country could acquire the more prestige they could wield across the globe.
• Empires wanted strategic territory to ensure access for their navies and armies around the world.
• The empire believed they must expand, thus they needed to be defended.
5. Economic
• With the Industrial Revolution taking place during the same time, governments and private companies contributed to find ways to maximize profits.
• Imperialized countries provided European factories and markets with natural resources (old and new) to manufacture products.
• Trading posts were strategically placed around imperialized countries to maximize and increase profits.
o Such places as the Suez Canal in Egypt which was controlled by the British provided strategic choke hold over many European powers.
o Imperial powers competed over the best potential locations for resources, markets, and trade.
History of Imperialism
• Ancient Imperialism 600 BCE-500 CE
o Roman Empire, Ancient China, Greek Empire, Persian Empire, Babylonian Empire.
• Middle Age Imperialism (Age of Colonialism-1400-1800s)
o Great Britain, Spain, Portugal, France, Netherlands (Dutch), Russia.
• Age of Imperialism 1870-1914
o Great Britain, Spain, Portugal, France, Germany, Belgium, Italy, Japan, United States, Ottoman Empire, Russia.
• Current Imperialism...?
o U.S. Military intervention (i.e. Middle East)
o Russia’s Invasion of Ukraine.
Imperialism Colonialism
• Refers to political or economic control, either legally or illegally. • Refers to where one nation assumes control over the other.
• Creating an empire, expanding into neighboring regions and expanding the dominance far outside its borders. • Where a country conquers and rules over other regions for exploiting resources from the conquered country for the conqueror's benefit.
• Foreign government controls/governs a territory without significant settlement. • Foreign government controls/governs the territory from within the land being colonized.
• Little to no new settlement established on fresh territory. • Movement to settle to fresh territory.
Age of Colonialism
WHEN?
• Started around the late 1400s and ended around the late 1700s/early 1800s.
WHY?
• Primary Reason: European countries, wished to find a direct trade route to Asia (China & India) and the East Indies.
o Quicker and relatively more effective than land routes over Asia.
• Secondary Reason: Empire expansion
(land power)
WHO?
• Countries involved: Great Britain, France, Spain, the Dutch & Portugal.
• Individuals’ knowns as Mercantilists believed that maintaining imperialized territory and colonizing the region could serve as a source of wealth, while personal motives by rulers, explorers, and missionaries could therefore promote their own agenda.
o This agenda being “Glory, God and Gold”.
Mercantilism
• Mercantilism was a popular and main economic system for many European nations during the 16th to 18th centuries.
• The main goal was to increase a nation’s wealth by promoting government rule of a nation’s economy for the purpose of enhancing state power at the expense of rival national power.
• It was the economic counterpart of political absolutism.
Why did mercantilists want colonies?
• Mercantilists believed that a country must have an excess of exports over imports.
• By colonizing territory, it provided the nation with indispensable wealth of precious raw materials.
• Therefore, the claimed territory served as a market and supplier of raw materials for the mother country. Which, in time, provided an excess of exports for the nation and thus created wealth.
o Development of Trading Companies to support this economic system. Hudson Bay Company – (1670). Controlled primarily North America.
o Dutch East Indie Trading Company (1682)
o East Indian Trading Company (1600)
o Royal African Trade Company (1672)
WHERE?
• European nations begun to colonize the America, India and the East Indies to create a direct trade route.
• Great Britain was the leading power in India, Australia and North America, South Africa.
• Spain colonized central and South America.
• French held Louisiana, coastal land of Africa and French Guinea.
• The Dutch built an empire in the East Indies.
• The Portuguese was able to take control of present-day Brazil and the southern tip of South America and Japan.
Age of Colonialism
• As countries started to imperialize these regions, eventually the concept of colonization took hold:
• This is what makes the Age of Colonialism extremely different!
End of Colonialism
• By 1800, colonialism became less popular
• Why?
o Revolutions (Spain, France & American)
o The Napoleonic Wars
o Struggle for nationalism and democracy.
o Exhausted all money and energy to supervise their colonies.
Waiting to wake again
• Imperialism would stay quiet for close to 50 years before Great Britain and France’s economies revitalized.
• The outbreak of the Industrial Revolution only encouraged and revitalized European nations to begin their conquest for new territory and resources.
Age of Imperialism
THE SCRAMBLE FOR AFRICA 1870-1914
Conditions Prior to Imperialism of Africa
European interest in exploiting Africa was minimal.
Their economic interests & profit in Africa primarily came through coastal trade that took place during the 1500-1700s.
The slave trade became the main source of European profit.
Furthermore, disease, political instability, lack of transportation and unpredictable climate all discouraged Europeans from seeking territory.
Slave Trade & the Trans-Atlantic Slave Voyages
Forced labor was not uncommon during the 13-17th Centuries. Africans and Europeans had been trading goods and people across the Mediteranea for centuries.
This all changed from 1526 to 1867, as a new system of slavery was introduced that became highly “commercialized, racialized and inherited”
By 1690, the America and West Indies saw approximately 30,000 African people shipped from Africa. A century later, that number grew to 85,000 people per year.
By 1867, approximately 12.5 million people (about twice the population of Arizona) left Africa in a slave ship.
What Changed?
1. End of the Slave Trade- Left a need for trade between Europe and Africa.
2. Innovation in technology- The steam engine and iron hulled boats allowed Europe
3. Discovery of new raw materials- Explorers located vast raw materials and resources and this only spurred imperialism with Europe in the wake of the Industrial Revolution.
4. Politics- Unification of Germany and Italy left little room to expand in Europe. Germany and Italy both needed raw materials to “catch up” with Britain and France so they looked to Africa.
The Scramble for Africa
The scramble started in 1870.
Although some coastal land had previously been acquired before 1870, the need for territory quickly accelerated as European countries looked t get deeper into Africa.
Within 20 years, nearly all continents were placed under imperialistic rule.
Who was Involved?
Great Britain
France
Germany
Italy
Portugal
Belgium
Spain (kind)
Violent Affairs
Violence broke out multiple times when European nations looked to claim the same territory.
Germ Chancellor. Otto van Bismarck. Attempted to avert the possibility of violence against the European powers.
In 1884, Bismarck organized a conference in Berlin for the European nations.
The Berlin Conference (1884-85)
The conference looked to set ground rules for future annexation of African territory by European Nations.
Annexation is the forcible acquisition and assertion of legal title over one state’s territory by another state, usually following military occupation of the territory.
From a distant perspective, it looked like it would reduce tensions among European nations and avert war.
At the heart of the meeting, these European countries negotiated their claims to African territory, made it official and then mapped their regions.
Furthermore, the leaders agreed to allow free trade among imperialized territory and some homework for negotiating future European claims in Africa was established.
Further Path
After the conference, european powers continued to expand their claims in Africa so that by 1900. 90% of the African territory had been claimed.
A Turn towards Colonization?
Upon the imperialization of African territory, European nations and little interest in African land unless it produced economic wealth.
Therefore, European governments put little effort and expertise into these imperialized regions.
In most cases, this emat a form of indirect rule. Thus, governing the natin without sufficient settlement and government from within the mother country.
Some Exceptions
There were some exemptions through in Africa as colonization was a necessary for some regions i n Africa.
Some regions where diamonds and gold were present. Government looked to protectorate the regions and establish rule and settlement in the regions.
Protectorates: A state controlled and protected by another state for defense against aggression and other law violations. Would
Some examples include South Africa, Botswana, Zimbabwe and Congo.
Conclusion
Although it may appear that the Berlin Conference averted war amid the African Scramble, imperialism eventually brought the world into worldwide conflict.
With the continued desire to create an empire by European nations. World War 1 would break out which can be linked to this quest at imperialism.
Updated 490d ago